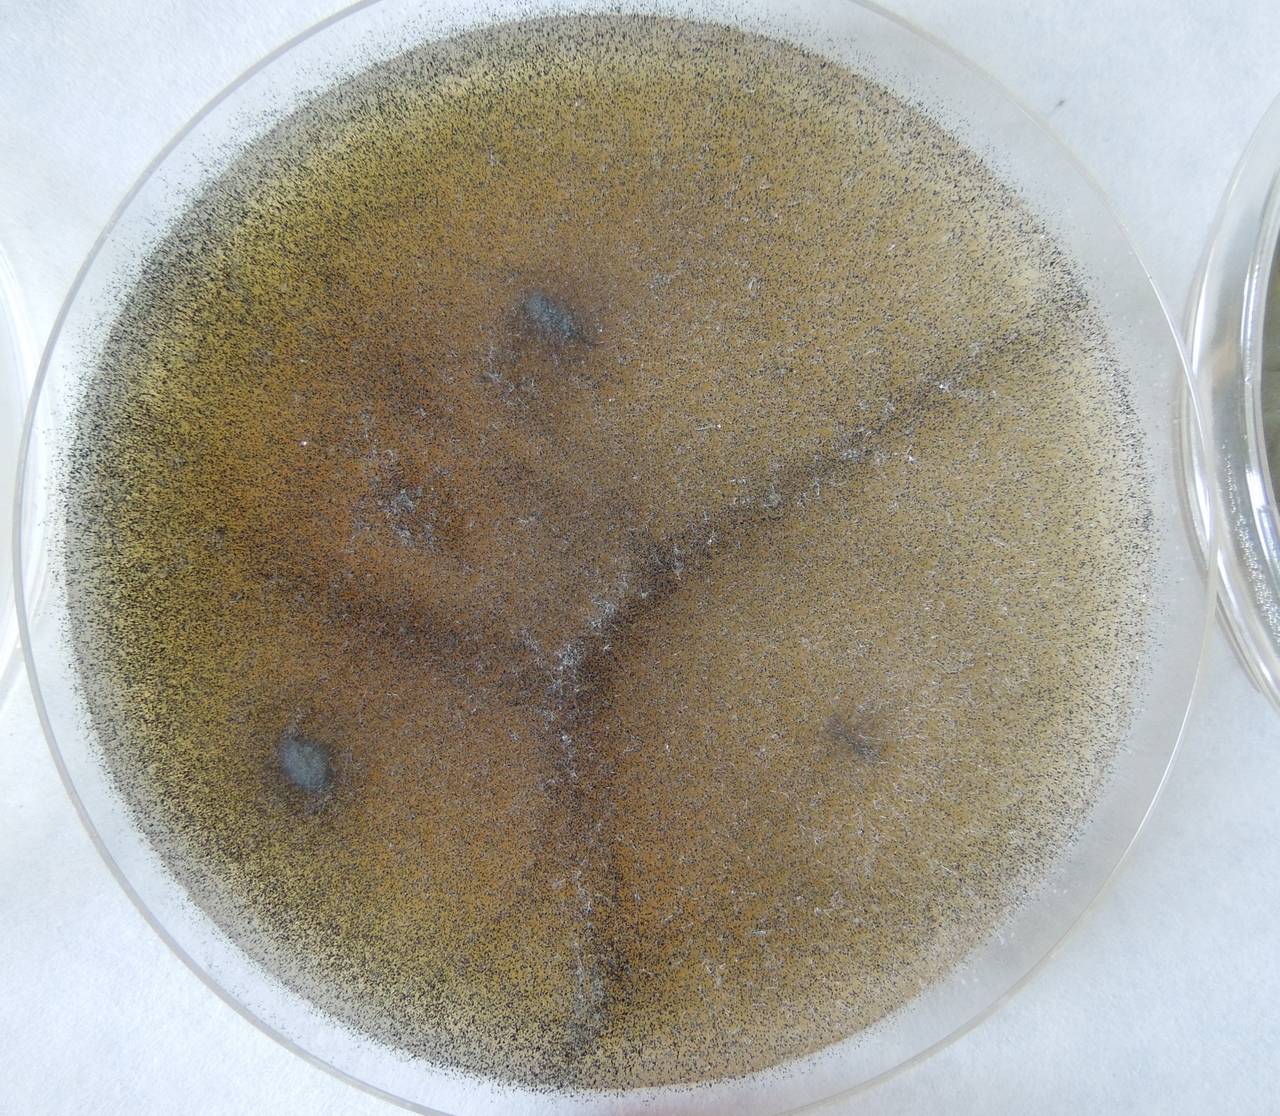

Фото Грибов Мукоров
Фото Грибов Мукоров 106 фото
Картинки Динозавров Карандашом
Красивые Голые Женщины Без Трусов Фото
Граница Между Странами Фото
Перо Ручка Картинки
Сорт Картофеля Маделина Характеристика Отзывы Фото
Известные Математики Фото
Скрытое Фото Девушек Порно
Кухонные Фасады Под Дерево Фото
Фото Женщин 90 Годов
Открыть Редактор Фото Онлайн Бесплатно